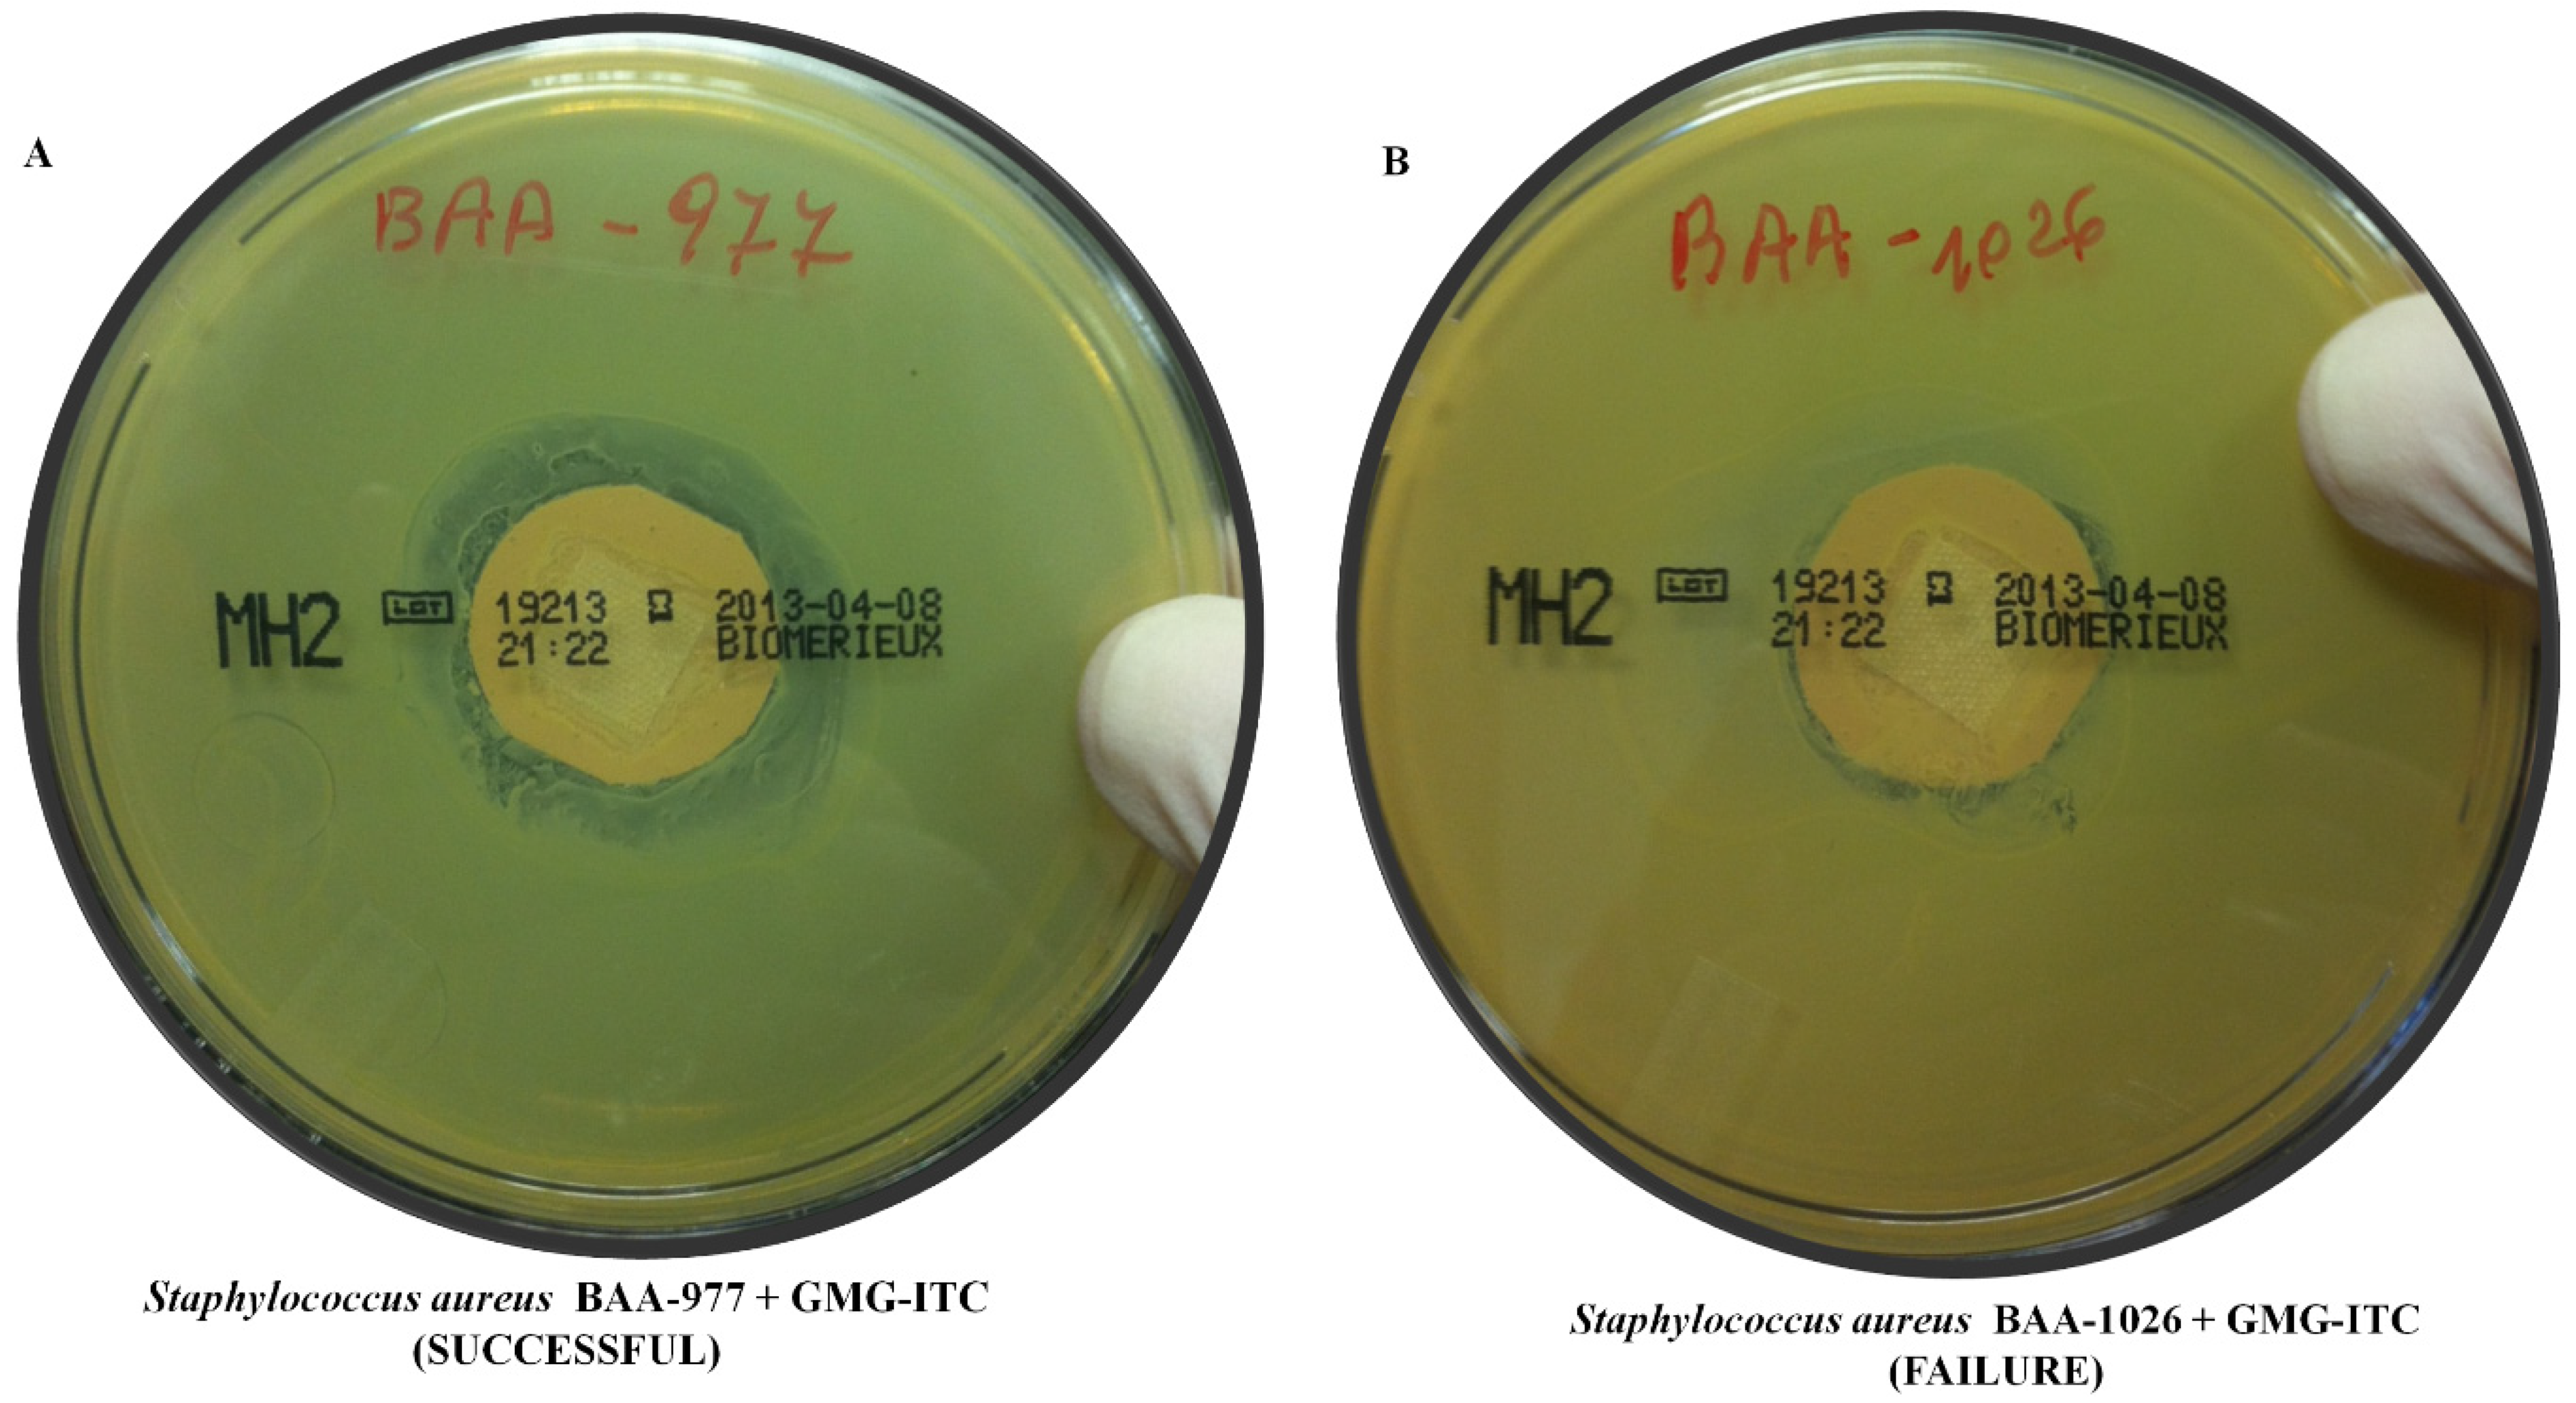
Molecules 18 14340 g001

Antibacterial Activity of Glucomoringin Bioactivated with Myrosinase against Two Important Pathogens Affecting the Health of Long-Term Patients in Hospitals
Abstract
:1. Introduction

2. Results and Discussion

3. Experimental
3.1. GMG and Myrosinase Purification
3.2. Enzyme Bioactivation of GMG and Patch Application
4. Conclusions
Conflicts of Interest
References
- Gueyrard, D.I.R.; Tatibouët, A.; Rollin, P. Glucosinolate chemistry: Synthesis of o-glycosylated derivatives of glucosinalbin. Eur. J. Org. Chem. 2010, 2010, 3657–3664. [Google Scholar] [CrossRef]
- Anwar, F.; Latif, S.; Ashraf, M.; Gilani, A.H. Moringa oleifera: A food plant with multiple medicinal uses. Phytother. Res. 2007, 21, 17–25. [Google Scholar] [CrossRef]
- Ndabigengeserea, A.N.K. Quality of water treated by coagulation using Moringa oleifera seeds. Water Res. 1998, 32, 781–791. [Google Scholar] [CrossRef]
- Padayachee, B. An overview of the medicinal importance of Moringaceae. J. Med. Plants Res. 2012, 6, 5831–5839. [Google Scholar]
- Biswas, S.C.A.; Das, J.; Roy, A.; Zahid Hosen, S.M. Pharmacological potentials of Moringa oleifera Lam.: A review. IJPSR 2012, 3, 305–310. [Google Scholar]
- Lalas, S.; Gortzi, O.; Athanasiadis, V.; Tsaknis, J.; Chinou, I. Determination of antimicrobial activity and resistance to oxidation of Moringa peregrina seed oil. Molecules 2012, 17, 2330–2334. [Google Scholar] [CrossRef]
- Dholvitayakhun, A.; Cushnie, T.P.; Trachoo, N. Antibacterial activity of three medicinal Thai plants against Campylobacter jejuni and other foodborne pathogens. Nat. Prod. Res. 2012, 26, 356–363. [Google Scholar] [CrossRef]
- Canton, R.; Ruiz-Garbajosa, P. Infections caused by multi-resistant Gram-positive bacteria (Staphylococcus aureus and Enterococcus spp.). Enferm. Infecc. Microbiol. Clin. 2013, 31, 543–551. [Google Scholar] [CrossRef]
- Atieno, W.; Wagai, S.; Arama, P.; Ogur, J. Antibacterial activity of Moringa oleifera and Moringa stenopetala methanol and n-hexane seed extracts on bacteria implicated in water borne diseases. Afr. J. Microbiol. Res. 2010, 5, 153–157. [Google Scholar]
- Caceres, A.; Cabrera, O.; Morales, O.; Mollinedo, P.; Mendia, P. Pharmacological properties of Moringa oleifera. 1: Preliminary screening for antimicrobial activity. J. Ethnopharmacol. 1991, 33, 213–216. [Google Scholar] [CrossRef]
- Chambers, H.F.; Deleo, F.R. Waves of resistance: Staphylococcus aureus in the antibiotic era. Nat. Rev. Microbiol. 2009, 7, 629–641. [Google Scholar] [CrossRef]
- Fry, D.E.; Barie, P.S. The changing face of Staphylococcus aureus: A continuing surgical challenge. Surg. Infect. 2011, 12, 191–203. [Google Scholar] [CrossRef]
- Velazquez-Meza, M.E.; Hernandez-Salgado, M.; Contreras-Cordero, J.F.; Perez-Cortes, P.; Villarreal-Trevino, L. Surveillance of methicillin-resistant Staphylococcus aureus causing nosocomial infections in five medical centers. Arch. Med. Res. 2013, 44, 570–574. [Google Scholar] [CrossRef]
- Screening for Methicillin-Resistant Staphylococcus aureus (MRSA): Future Research Needs. Future Research Needs Paper No. 40. (Prepared by the Blue Cross and Blue Shield Association Technology Evaluation Center Evidence-based Practice Center under Contract No. 290-2007-10058-I.). Available online: http://effectivehealthcare.ahrq.gov/ehc/products/538/1552/MRSA-screening-future-130905.pdf (accessed on 15 November 2013).
- Reid, K.C.; Cockerill, I.F.; Patel, R. Clinical and epidemiological features of Enterococcus casseliflavus/flavescens and Enterococcus gallinarum bacteremia: A report of 20 cases. Clin. Infect. Dis. 2001, 32, 1540–1546. [Google Scholar] [CrossRef]
- Tang, H.J.; Chen, C.C.; Zhang, C.C.; Su, B.A.; Li, C.M.; Weng, T.C.; Chiang, S.R.; Ko, W.C.; Chuang, Y.C. In vitro efficacy of fosfomycin-based combinations against clinical vancomycin-resistant Enterococcus isolates. Diagn. Microbiol. Infect. Dis. 2013, 77, 254–257. [Google Scholar] [CrossRef]
- Iaria, C.; Stassi, G.; Costa, G.B.; di Leo, R.; Toscano, A.; Cascio, A. Enterococcal meningitis caused by Enterococcus casseliflavus. First case report. BMC Infect. Dis. 2005, 5, 3. [Google Scholar]
- Brunelli, D.; Tavecchio, M.; Falcioni, C.; Frapolli, R.; Erba, E.; Iori, R.; Rollin, P.; Barillari, J.; Manzotti, C.; Morazzoni, P.; et al. The isothiocyanate produced from glucomoringin inhibits NF-kB and reduces myeloma growth in nude mice in vivo. Biochem. Pharmacol. 2010, 79, 1141–1148. [Google Scholar] [CrossRef]
- European Economic Community, Commisssion Regulation. Oilseeds—determination of glucosinolates high performance liquid chromatography. Off. J. Eur. Comm. 1990, L170, 27–34. [Google Scholar]
- Pessina, A.; Thomas, R.M.; Palmieri, S.; Luisi, P.L. An improved method for the purification of myrosinase and its physicochemical characterization. Arch. Biochem. Biophys. 1990, 280, 383–389. [Google Scholar] [CrossRef]
- Abdull Razis, A.F.; Bagatta, M.; de Nicola, G.R.; Iori, R.; Ioannides, C. Up-regulation of cytochrome P450 and phase II enzyme systems in rat precision-cut rat lung slices by the intact glucosinolates, glucoraphanin and glucoerucin. Lung Cancer 2011, 71, 298–305. [Google Scholar] [CrossRef]
- Williams, L. Moringa oleifera: Could this be an answer to our need for an alternative to fighting drug-resistance and chronic infections? Med. Aromat. Plants 2013, 2, 1–3. [Google Scholar]
- Sample Availability: Samples of the compounds are available from the authors.
© 2013 by the authors; licensee MDPI, Basel, Switzerland. This article is an open access article distributed under the terms and conditions of the Creative Commons Attribution license (http://creativecommons.org/licenses/by/3.0/).
Share and Cite
Galuppo, M.; Nicola, G.R.D.; Iori, R.; Dell'Utri, P.; Bramanti, P.; Mazzon, E. Antibacterial Activity of Glucomoringin Bioactivated with Myrosinase against Two Important Pathogens Affecting the Health of Long-Term Patients in Hospitals. Molecules 2013, 18, 14340-14348. https://doi.org/10.3390/molecules181114340
Galuppo M, Nicola GRD, Iori R, Dell'Utri P, Bramanti P, Mazzon E. Antibacterial Activity of Glucomoringin Bioactivated with Myrosinase against Two Important Pathogens Affecting the Health of Long-Term Patients in Hospitals. Molecules. 2013; 18(11):14340-14348. https://doi.org/10.3390/molecules181114340
Chicago/Turabian StyleGaluppo, Maria, Gina Rosalinda De Nicola, Renato Iori, Pia Dell'Utri, Placido Bramanti, and Emanuela Mazzon. 2013. "Antibacterial Activity of Glucomoringin Bioactivated with Myrosinase against Two Important Pathogens Affecting the Health of Long-Term Patients in Hospitals" Molecules 18, no. 11: 14340-14348. https://doi.org/10.3390/molecules181114340
APA StyleGaluppo, M., Nicola, G. R. D., Iori, R., Dell'Utri, P., Bramanti, P., & Mazzon, E. (2013). Antibacterial Activity of Glucomoringin Bioactivated with Myrosinase against Two Important Pathogens Affecting the Health of Long-Term Patients in Hospitals. Molecules, 18(11), 14340-14348. https://doi.org/10.3390/molecules181114340

